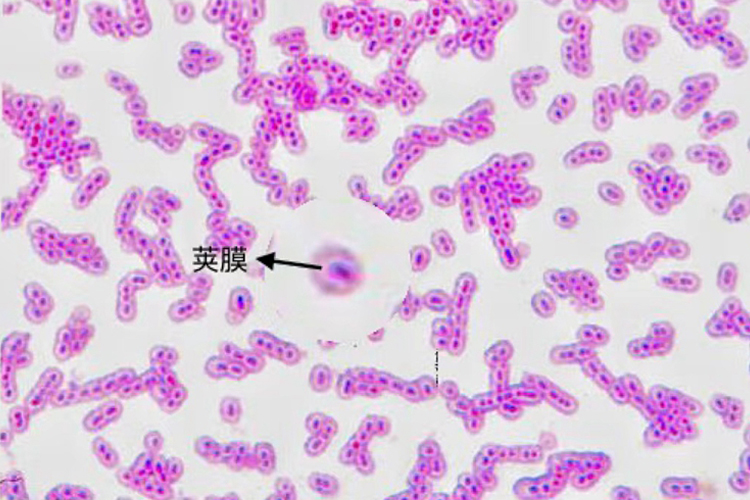
肺炎链球菌荚膜图 肺炎链球菌荚膜图

概述
肺炎荚膜主要指肺炎链球菌荚膜,其主要为肺炎链球菌细胞外壁包围的一层黏液性物质。
肺炎链球菌荚膜中存在荚膜多糖抗原,荚膜是肺炎链球菌的主要致病物质。
性状
肺炎链球菌呈矛头状,宽端相对,尖端背对,多成双排列,在患者痰液中可见短链排列,其为革兰阳性球菌,无鞭毛,无芽孢,有较厚荚膜,荚膜主要为肺炎链球菌在细胞壁外包围的一层黏液性物质,在荚膜中存在具有特异性的荚膜多糖抗原。
致病性
肺炎链球菌的致病力,主要是荚膜的抗吞噬作用。有荚膜的光滑型菌株有毒力,荚膜中的荚膜多糖本身对机体无直接毒性作用,但可与血液中相应抗体发生特异性结合,从而消耗体内的抗荚膜特异性抗体,从而引起疾病的发生。
参考文献
[1]阳莉.病原生物与免疫学.第2版[M].北京.中国医药科技出版社,2019.67-68.
[2]叶千红.实验诊断学彩色图谱[M].湖北.湖北科学技术出版社,2018.93.
[3]叶群芳.病原生物与免疫学[M].湖北.华中科技大学出版社,2019.45.
展开






